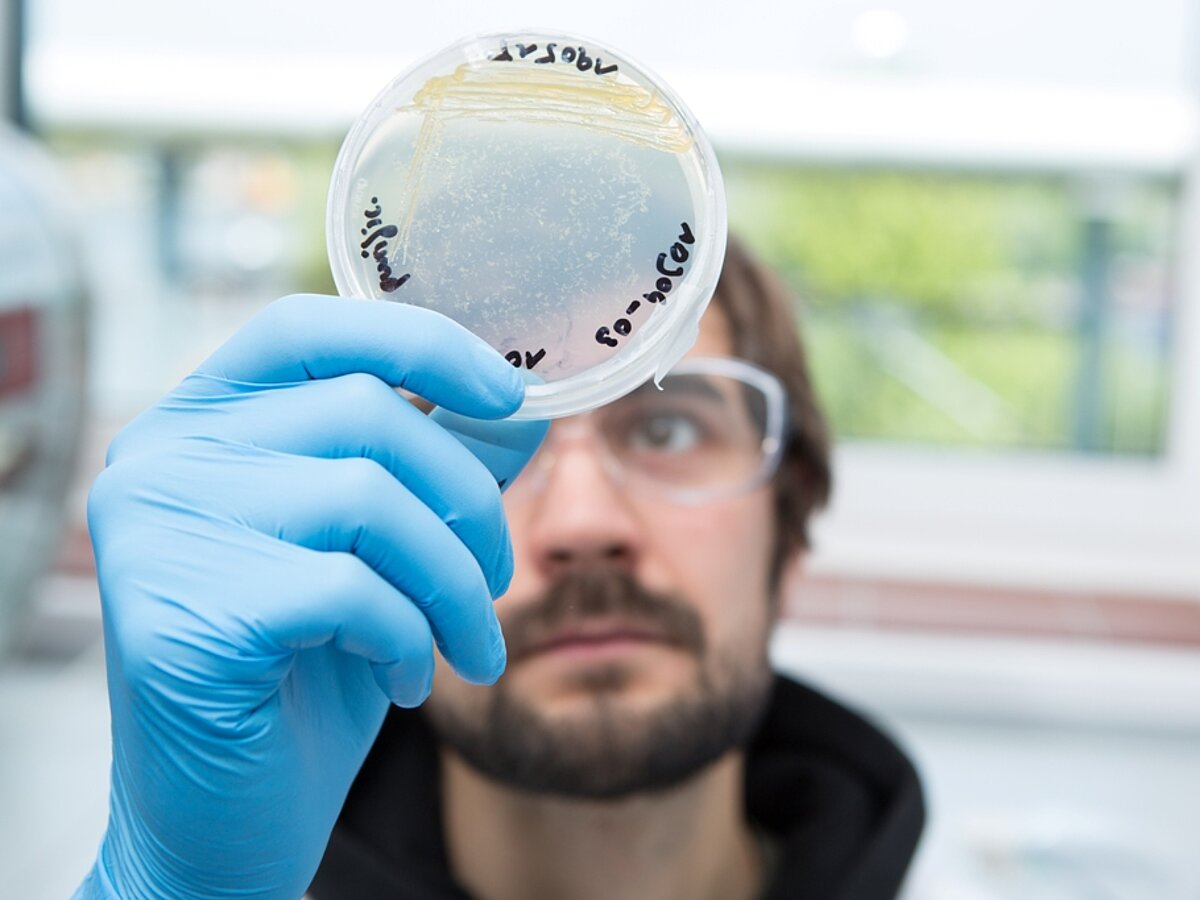

Teaching (letcures, seminars, practicals)

Courses (lectures, seminars, practicals etc.)
Summer semester:
MNF-bioc-274 New Trends in Marine Biodiscovery
Venue: GEOMAR-Eastshore, Wischhofstraße 1 - 3, 24148 Kiel
MNF-bioc-202 Advanced Practical Course in Biological Oceanography - Practical with exercises
Venue: GEOMAR-Eastshore, Wischhofstraße 1 - 3, 24148 Kiel, ENB (Building 5), RU MN labs (multiple)
Winter semester:
MNF-bioc-374 New Trends in Marine Biotechnology
Venue: GEOMAR-Eastshore, Wischhofstraße 1 - 3, 24148 Kiel
Start date: 03.11.2025
mondays - 05:00-07:00pm
MNF-bioc-360 Marine biodiscovery and biotechnology - Practical
Venue: GEOMAR-Eastshore, Wischhofstraße 1 - 3, 24148 Kiel, ENB (Building 5), RU MN labs (multiple)
Date: 23.02. - 06.03.2026
MNF-bioc-307 Current Topics in Marine Ecology - seminar and lecture
Venue: GEOMAR-Eastshore, Wischhofstraße 1 - 3, 24148 Kiel
Start date: 30.10.2025
tuesdays and thursdays - 09:00-11:00am
MNF-bioc-303 Current Topics in Ecology & Evolution - seminar and lecture
Venue: GEOMAR-Eastshore, Wischhofstraße 1 - 3, 24148 Kiel
Start date: 30.10.2025
mondays and thursdays - 02.00-04:00pm